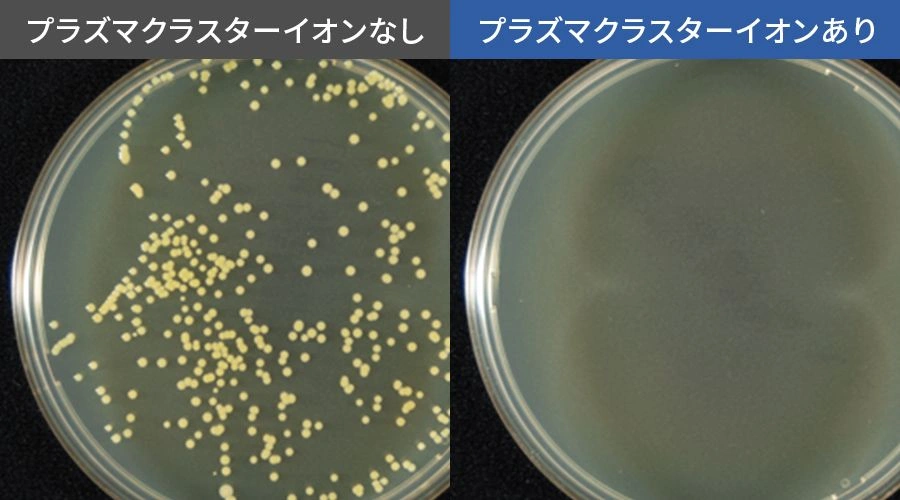

プラズマクラスター
きれいな冷気が冷蔵室を循環
毎日使う冷蔵室だから食品の鮮度や使いやすさはもちろん、清潔さにもこだわりたい。プラズマクラスターイオン発生ユニット搭載で、きれいな冷気が冷蔵室を循環し、清潔に保ちます。

浮遊菌を除菌※1※3
プラズマクラスターイオンが、冷蔵室内に浮遊する菌の細胞表面のタンパク質を分解、除菌します。※1※3
- ※1浮遊菌除菌効果(1000Lのボックス内での実験結果。実使用空間での実証結果ではありません。)【試験依頼先】(一財)石川県予防医学協会【試験成績書】第14000609号【試験方法】1000Lのボックス内にプラズマクラスターイオンを放出し、その後、浮遊菌をエアーサンプラーを用いて採取し、生菌数を測定(プラズマクラスターイオン濃度:ダクト内200,000個/cm3)【試験対象】浮遊した1種類の菌【対象場所】冷蔵室内【試験結果】約73分で除去率99%以上
付着菌を除菌※2※3
プラズマクラスターイオンが冷蔵室内に放出され、庫内に付着している菌まで除菌します。※2※3
- ※2付着菌除菌効果(100Lのボックス内での実験結果。実使用空間での実証結果ではありません。)【試験依頼先】(一財)石川県予防医学協会【試験成績書】第H1600196K号【試験方法】100Lのボックス内に菌を塗布した寒天培地を配置し、プラズマクラスターイオン放出6日後の生菌数を測定(プラズマクラスターイオン濃度:50,000個/cm³)【対象場所】冷蔵室内【試験結果】6日間で除去率99%以上
プラズマクラスター集中シャワーモード
ドア開閉が多い時、ドアを長く開けた時などを分析し、生活リズムに合わせたタイミングで冷蔵室内に通常より多くのイオンを放出し、清潔にします。
